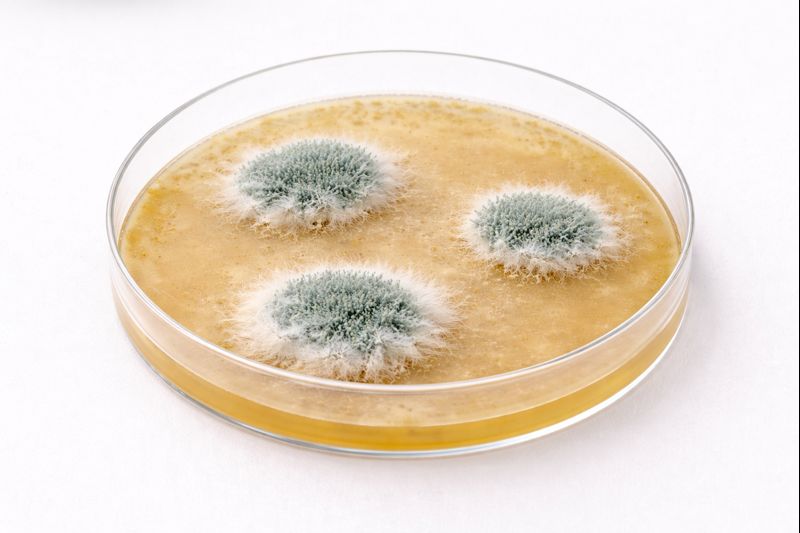

人は、見えるものを信じやすい。
形があり、 境界があり、 動きが確認できるもの。
だがカビは、 見えない時間の中で進行する生命だ。
その存在をどう理解するかは、 世界をどう捉えるかという姿勢に直結している。
🦠 目次
👁️ 1. 見えないものへの不安
カビは、 突然現れたように見える。
だが実際には、 長い時間をかけて進行している。
人が不安を感じるのは、 その過程を知覚できないからだ。
見えないものは、 予測できない。
予測できないものは、 恐れられる。
カビに向けられる不安の多くは、 生命そのものより、 不可視性に向けられている。
📐 2. 管理という認識の道具
見えないものに対して、 人は「管理」という方法を選んできた。
数値、基準、 許容範囲。
それらは、 不安を減らすための道具だ。
だが同時に、 世界を単純化する枠組みでもある。
管理できるか、 できないか。
その二分法は、 生命の多様なあり方を 切り落とすこともある。
🌍 3. 生命を測るということ
生命を測るという発想は、 近代的な世界観と深く結びついている。
量、速度、 増減。
それらは、 比較と制御を可能にする。
だがカビのような生命は、 測定の外側に滲み出る。
止まっているようで進み、 進んでいるようで待つ。
カビは、 測りきれない生命が存在することを、 静かに示している。
🫧 詩的一行
カビは、見えないまま進む生命を、世界に思い出させる。
コメント